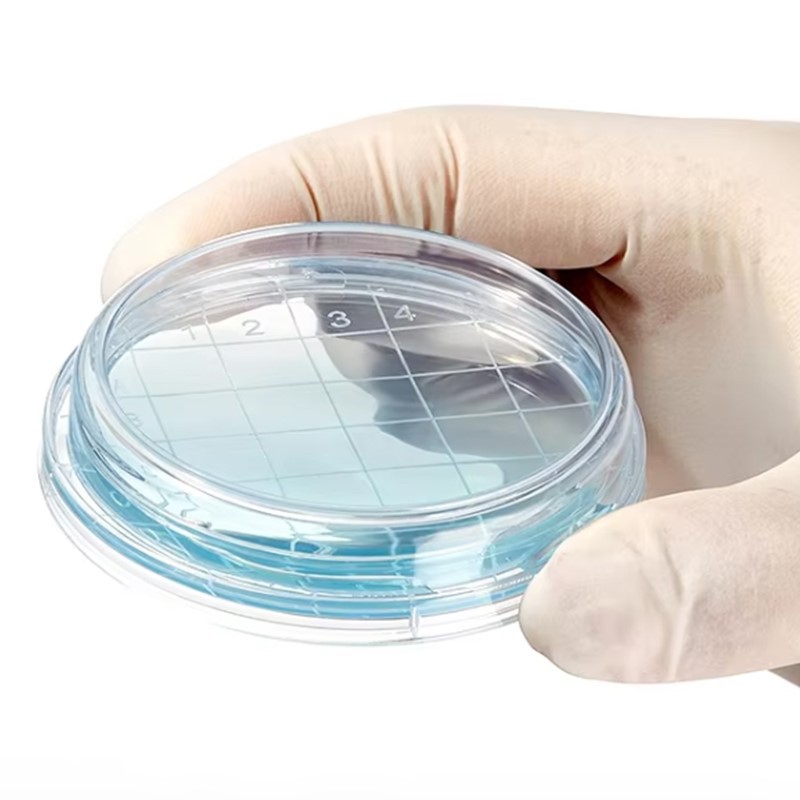
3 3

55ММ Родац контактна плоча за стерилно узорковање
Спецификација производа:
| Назив производа | Родац Плате |
| Материјал | ПС (полистирен) |
| Величина | Пречник поклопца: 55 мм Пречник плоче: 55 мм |
| Боја | Транспарент |
| Пакет | 10ком/кеса 500ком/картон |
| одлика | ЕО стерилан, спреман за употребу, прозирно дипломиран |
| Аппицатион | Користи се за различите микробне културе, произвођач медијума за културу |
Слике производа:

Профил компаније:
Цхангде БКМАМ Биотецхнологи Цо., Лтд. је специјализован за лабораторијски потрошни материјал основан 2015. године, већ годинама се посвећујемо истраживању и развоју, производњи, продаји и постпродајним услугама лабораторијског материјала, уређаја итд.БКМАМ је произвођач лабораторијског и медицинског потрошног материјала, производи покривени пластичним лабораторијским потрошним материјалом, стакленим лабораторијским потрошним материјалом,
руковање течностима, микро био и ћелијска култура, предаја узорака, биолошки реагенси и друге серије производа.
Главни купци су универзитети, биомедицинске компаније, установе за тестирање, болнице, центри за контролу болести, агенти и дистрибутери у индустрији.
Тренутно имамо један оперативни центар, један центар за истраживање и развој, производни и продајни центар и два складишта и логистичка центра, као и широк спектар продајних агената који покривају целу Кину. Компанију сада води група младих људи са великом амбицијом и визијом, који су дипломирали на врхунским универзитетима у Кини.
Поздрављамо нове и старе купце из свих сфера да нам се јаве за будуће пословне односе и заједнички успех!
Наше предности:
1. на једном месту за сав лабораторијски пластични потрошни материјал, комплетан асортиман и разни производи доступни;
2.фацтори директна продаја, најконкурентнија цена и услуга;
3. професионални и брзи тим за развој калупа;
4. Радионица за пречишћавање нивоа 100000, машина за стерилизацију ЕО, аутоматска машина за паковање, аутоматска машина за пуњење боца, машина за убризгавање пластике итд.
5. најбољи пакет довољно јак да заштити производе и уштеди простор да уштеди трошкове испоруке.
6. вишеструки канал испоруке по вашем избору, брза и практична испорука
Наша фабрика:





сертификација:

Изложба:


Достава и испорука:

ФАК:
1. Могу ли да посетим вашу фабрику?
Наравно, срдачно поздравите вашу посету БКМАМ-у. Покушајте да прво контактирате нашег представника продаје путем е-поште или телефона. Ми ћемо заказати термин и најразумније планирати ваш превоз.
2. Можете ли прилагодити за нас?
Да, можемо прилагодити величину, паковање, боју, лого, материјал за вас посебно на основу наруџби. И такође направите дизајн према вашој детаљној спецификацији.
3. Која је ваша минимална количина поруџбине?
Веома низак МОК за уобичајене артикле. За прилагођене ставке, зависи од различитих захтева.
4. Да ли нудите узорке пре поруџбине и колико кошта?
Да, можемо да обезбедимо неколико бесплатних узорака за проверу квалитета пре поруџбине, али експресни трошак би требало да одговори са ваше стране.
5. Зашто изабрати нас?
Професионални произвођач лабораторијског потрошног материјала дуги низ година. Одличан и стабилан квалитет са најбољим перформансама трошкова. Благовремена испорука загарантована. Вредност компаније је Решите проблем, пружите услугу, стекните поверење.
Контакт:
Контакт особа: Вера Цхан
Моб. & Вецхат:+86 199 1131 0732
ВхатсАпп:+86 189 7576 9017
Email:vianna@bkmbio.com
Popularne oznake: родац контактне плоче, Кина, произвођачи, фабрика, велепродаја, цена



















